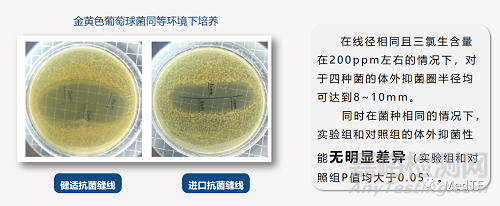

健適宣布其自主研發(fā)的“三氯生涂層抗菌縫合線(簡(jiǎn)稱:健適抗菌縫線)” 獲得NMPA批準(zhǔn)上市(注冊(cè)證號(hào):國(guó)械注準(zhǔn)20233021266),這是首次本土企業(yè)開(kāi)發(fā)出抗菌縫線�,并在國(guó)內(nèi)上市。健適抗菌縫線上市打破國(guó)外長(zhǎng)達(dá)20多年來(lái)的壟斷����,這是國(guó)產(chǎn)縫線品牌一次重大進(jìn)步。
根據(jù)統(tǒng)計(jì)在外科手術(shù)中����,手術(shù)部位感染(SSI)是常見(jiàn)的并發(fā)癥之一����,國(guó)內(nèi)發(fā)生率約6-7%����,占所有院內(nèi)感染的14%��。研究表明����,SSI會(huì)延長(zhǎng)7-19.5天住院時(shí)間�,增加了5倍術(shù)后再就診率��,并且導(dǎo)致3%的病人死亡�。
根據(jù)醫(yī)學(xué)文獻(xiàn)分析統(tǒng)計(jì)��,在手術(shù)中使用含三氯生涂層的縫線��,可減少約30%的手術(shù)部位感染發(fā)生率����。因此,在世界衛(wèi)生組織(WHO)發(fā)布的《預(yù)防手術(shù)部位感染全球指南》����、中華醫(yī)學(xué)會(huì)外科學(xué)分會(huì)發(fā)布的《中國(guó)手術(shù)部位感染預(yù)防指南》等多個(gè)權(quán)威指南中,都明確提到并推薦在手術(shù)縫合時(shí)使用含抗菌劑的縫線��。
同時(shí)多個(gè)大型臨床研究也證實(shí)抗菌縫線臨床價(jià)值�,能夠有效降低手術(shù)切口部位感染(SSI)�。例如在2015年《Infection Control and Hospital Epidemiology》雜志上也發(fā)表了一篇關(guān)于三氯生涂層縫線減少SSI風(fēng)險(xiǎn)的系統(tǒng)回顧與meta分析�,該分析包括29個(gè)試驗(yàn),其中22個(gè)隨機(jī)對(duì)照試驗(yàn)����,7個(gè)非隨機(jī)對(duì)照試驗(yàn)����。結(jié)果表明三氯生涂層縫線能降低26%手術(shù)患者SSI風(fēng)險(xiǎn)����,特別是降低腹部手術(shù)SSI的風(fēng)險(xiǎn)。
健適抗菌縫線推出是對(duì)健適縫線家族完美補(bǔ)充��,健適圍繞縫線已經(jīng)開(kāi)發(fā)出可吸收系列縫線�、非可吸收系列縫線和可吸收外科倒刺線。隨著健適縫線家族日趨完善�,也開(kāi)始向強(qiáng)生、美敦力等巨頭壟斷地位發(fā)起挑戰(zhàn)����。并在集采大環(huán)境配合下海外巨頭壟斷地位開(kāi)始松動(dòng)����,例如在7月份河北省牽頭三明采購(gòu)聯(lián)盟開(kāi)展的19類耗材集采中,健適的可吸收外科倒刺線力拔頭籌�,獲得20%的保底量。在此之前這是不可想象的��,強(qiáng)生����、美敦力等海外公司憑借自己發(fā)達(dá)銷售網(wǎng)絡(luò)渠道和市場(chǎng)影響力占據(jù)國(guó)內(nèi)95%以上市場(chǎng)份額?�,F(xiàn)在隨著像健適等國(guó)內(nèi)創(chuàng)新醫(yī)療器械公司崛起��,開(kāi)始打破海外企業(yè)壟斷�,希望未來(lái)獲得更多市場(chǎng)份額����。也期待未來(lái)健適等國(guó)內(nèi)創(chuàng)新醫(yī)療器械公司能夠?qū)?guó)內(nèi)醫(yī)療技術(shù)反向輸出到海外,就像華為在通信領(lǐng)域一樣�。
健適抗菌縫線
健適抗菌縫線是由硬質(zhì)纖維不銹鋼針及PGLA材質(zhì)縫線組成,縫線涂層含有乙交酯和丙交酯共聚物和硬脂酸鈣�,縫線上含有抑菌劑三氯生,可在縫線周圍形成抑菌區(qū)�,對(duì)金葡菌、表葡菌�、耐藥金葡菌、耐藥表葡菌有明顯作用�,可以有效降低術(shù)后SSI風(fēng)險(xiǎn)。
實(shí)驗(yàn)顯示��,該款產(chǎn)品的體外抑菌性能與進(jìn)口抗菌縫線無(wú)明顯差異��。在體外斷裂強(qiáng)力和體內(nèi)降解抗張也表現(xiàn)出與進(jìn)口抗菌縫線相近的性能�。與進(jìn)口品牌對(duì)比
健適
健適是一家國(guó)內(nèi)醫(yī)療器械公司,其致力于打造開(kāi)放的醫(yī)療科技平臺(tái)����,在全球范圍內(nèi)建立創(chuàng)新網(wǎng)絡(luò)����。以開(kāi)放式創(chuàng)新平臺(tái)為基礎(chǔ)��,健適積極整合國(guó)內(nèi)外資源、促進(jìn)上下游合作����,持續(xù)打造豐富的�、適應(yīng)中國(guó)病患需求的高性價(jià)比產(chǎn)品����。